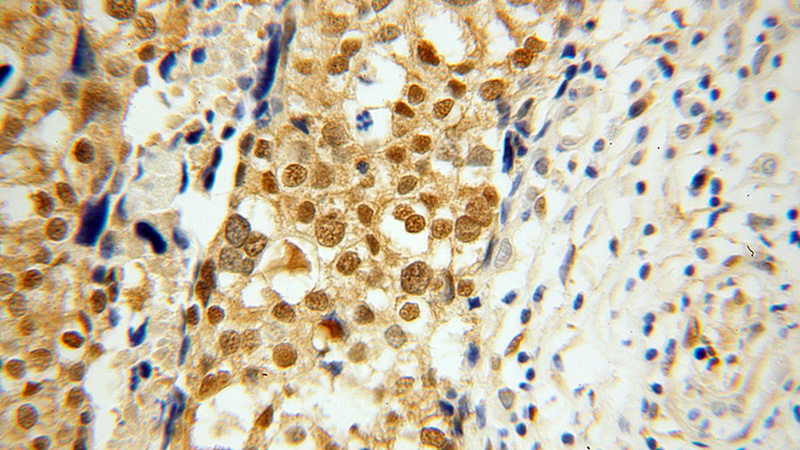

-
Product Name
YAP1 antibody
- Documents
-
Description
YAP1 Rabbit Polyclonal antibody. Positive WB detected in HeLa cells, MCF-7 cells. Positive IP detected in NIH/3T3 cells. Positive IF detected in HepG2 cells. Positive IHC detected in human ovary tumor tissue. Positive FC detected in NIH3T3 cells. Observed molecular weight by Western-blot: 65-70 kDa
-
Tested applications
ELISA, IHC, FC, IF, IP, WB
-
Species reactivity
Human, Mouse, Zebrafish; other species not tested.
-
Alternative names
65 kDa Yes assOCiated protein antibody; YAP antibody; YAP1 antibody; YAP2 antibody; YAP65 antibody; YKI antibody; Yorkie homolog antibody
- Immunogen
-
Isotype
Rabbit IgG
-
Preparation
This antibody was obtained by immunization of YAP1 recombinant protein (Accession Number: NM_001130145). Purification method: Antigen affinity purified.
-
Clonality
Polyclonal
-
Formulation
PBS with 0.02% sodium azide and 50% glycerol pH 7.3.
-
Storage instructions
Store at -20℃. DO NOT ALIQUOT
-
Applications
Recommended Dilution:
WB: 1:500-1:5000
IP: 1:200-1:2000
IHC: 1:20-1:200
IF: 1:20-1:200
-
Validations
Immunohistochemical of paraffin-embedded human ovary tumor using Catalog No:116880(YAP1 antibody) at dilution of 1:100 (under 40x lens)

FC result of YAP antibody (Catalog No:116880) with Min6 and NIH3T3 cell by Sarvetnick Lab, UNMC

HeLa cells were subjected to SDS PAGE followed by western blot with Catalog No:116880(YAP1 Antibody) at dilution of 1:1000

IP Result of anti-YAP1 (IP:Catalog No:116880, 3ug; Detection:Catalog No:116880 1:700) with NIH/3T3 cells lysate 1200ug.

Immunofluorescent analysis of HepG2 cells using Catalog No:116880(YAP1 Antibody) at dilution of 1:50 and Rhodamine-Goat anti-Rabbit IgG
-
Background
Yes-associated protein 1 (YAP1) is a transcriptional regulator which can act both as a coactivator and a corepressor and is the critical downstream regulatory target in the Hippo signaling pathway that plays a pivotal role in organ size control and tumor suppression by restricting proliferation and promoting apoptosis. The core of this pathway is composed of a kinase cascade wherein STK3/MST2 and STK4/MST1, in complex with its regulatory protein SAV1, phosphorylates and activates LATS1/2 in complex with its regulatory protein MOB1, which in turn phosphorylates and inactivates YAP1 oncoprotein and WWTR1/TAZ. Plays a key role to control cell proliferation in response to cell contact. Phosphorylation of YAP1 by LATS1/2 inhibits its translocation into the nucleus to regulate cellular genes important for cell proliferation, cell death, and cell migration. The presence of TEAD transcription factors are required for it to stimulate gene expression, cell growth, anchorage-independent growth, and epithelial mesenchymal transition (EMT) induction. Isoform 2 and isoform 3 can activate the C-terminal fragment (CTF) of ERBB4 (isoform 3).Increased expression seen in some liver and prostate cancers. Isoforms lacking the transactivation domain found in striatal neurons of patients with Huntington disease (at protein level).It is actived by phosphorylation and degradated by ubiquitination (20048001).This antibody is a rabbit polyclonal antibody.
-
References
- Zhang T, Zhang J, You X. Hepatitis B virus X protein modulates oncogene Yes-associated protein by CREB to promote growth of hepatoma cells. Hepatology (Baltimore, Md.). 56(6):2051-9. 2012.
- Gao Y, Wang Y, Feng J. A hairpin within YAP mRNA 3'UTR functions in regulation at post-transcription level. Biochemical and biophysical research communications. 459(2):306-12. 2015.
- Wang Z, Wu Y, Wang H. Interplay of mevalonate and Hippo pathways regulates RHAMM transcription via YAP to modulate breast cancer cell motility. Proceedings of the National Academy of Sciences of the United States of America. 111(1):E89-98. 2014.
- Hu J, Sun S, Jiang Q. Yes-associated protein (yap) is required for early embryonic development in zebrafish (danio rerio). International journal of biological sciences. 9(3):267-78. 2013.
- George NM, Day CE, Boerner BP, Johnson RL, Sarvetnick NE. Hippo signaling regulates pancreas development through inactivation of Yap. Molecular and cellular biology. 32(24):5116-28. 2012.
- Yu SJ, Hu JY, Kuang XY. MicroRNA-200a promotes anoikis resistance and metastasis by targeting YAP1 in human breast cancer. Clinical cancer research : an official journal of the American Association for Cancer Research. 19(6):1389-99. 2013.
- Sun T, Pepling ME, Diaz FJ. Lats1 Deletion Causes Increased Germ Cell Apoptosis and Follicular Cysts in Mouse Ovaries. Biology of reproduction. 93(1):22. 2015.
- Li L, Fang R, Liu B. Deacetylation of tumor-suppressor MST1 in Hippo pathway induces its degradation through HBXIP-elevated HDAC6 in promotion of breast cancer growth. Oncogene. 2015.
Related Products / Services
Please note: All products are "FOR RESEARCH USE ONLY AND ARE NOT INTENDED FOR DIAGNOSTIC OR THERAPEUTIC USE"
